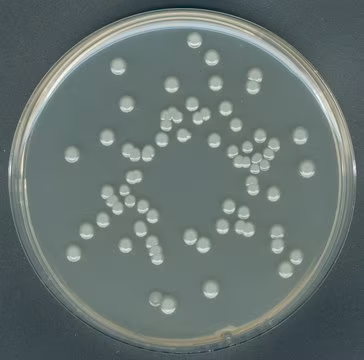
产品细节图片1

相关产品推荐更多 >
万千商家帮你免费找货
0 人在求购买到急需产品
- 详细信息
- 文献和实验
- 技术资料
- 库存:
999
- 保修期:
可咨询
- 现货状态:
可咨询
- 供应商:
默克
- 规格:
1.05463.0500
一般描述
平板计数琼脂(Plate Count Agar),也称为胰蛋白胨葡萄糖酵母琼脂或酪蛋白胨右旋糖酵母琼脂,是颗粒状培养基。不含任何抑制剂或指示剂,营养成分相对丰富。酪蛋白胨(胰蛋白胨)的酶解产物游离氨基酸含量高,是培养基的氮源。酵母提取物主要提供B族复合维生素。葡萄糖是细菌生长的能源,而琼脂是固化剂。我们的粒状培养基具有多种优势,如稠度出色、溶解速度快、保质期更长,安全性更好以及易于处理。
应用
Plate Count Agar适用于测定牛乳、乳制品、食品和动物饲料、水、饮料和其他材料中的总微生物含量。
风险提示:丁香通仅作为第三方平台,为商家信息发布提供平台空间。用户咨询产品时请注意保护个人信息及财产安全,合理判断,谨慎选购商品,商家和用户对交易行为负责。对于医疗器械类产品,请先查证核实企业经营资质和医疗器械产品注册证情况。
文献和实验相关实验
肝素蛋白多糖(HSPG)。前三种蛋白的摩尔含量一般差不多相等,HSPG的含量则偏低,但是鉴于ECM Gel是生物提取物,我们不能确定各成分的准确浓度。 ECM Gel来源于细胞裂解物还是真正的细胞基质? ECM Gel基质胶由整个EHS肿瘤(不是分离细胞)制备而成。它是肿瘤的全提取产物。 ECM基质胶与Matrigel®(Corning)、Geltrex®(Thermo)或Cultrex®(Trevigen)一样吗? ECM Gel基质胶是这些产品的生物等效品,ECM基质胶(E6909,E1270)由默克
技术资料暂无技术资料 索取技术资料
1.05463.0500 Merck 默克 GranuCult® 平板计数琼脂
¥11561.66









